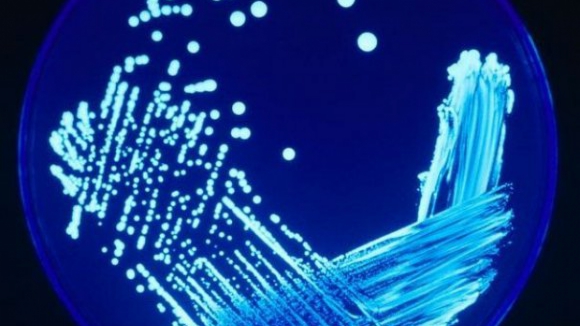
Legionella: Cinco mortos e 233 infectados

Legionella: Cinco mortos e 233 infectados
Porto Canal
A Direção-geral da Saúde (DGS) revelou que até às 15:00 de hoje já tinham morrido cinco pessoas vítimas de legionella, havendo 233 casos registados.
Em comunicado, a DGS adianta ainda que se encontram internadas nos cuidados intensivos 38 pessoas.
Do total de 233 casos, 228 são na região de Lisboa e Vale do Tejo, três na região centro e dois na região norte.
“Todos os casos reportados têm ligação epidemiológica ao surto que decorre em Vila Franca de Xira. As freguesias de Vialonga, Póvoa de Santa Iria e Forte da Casa são as que continuam a registar a maior incidência”, refere a nota.

